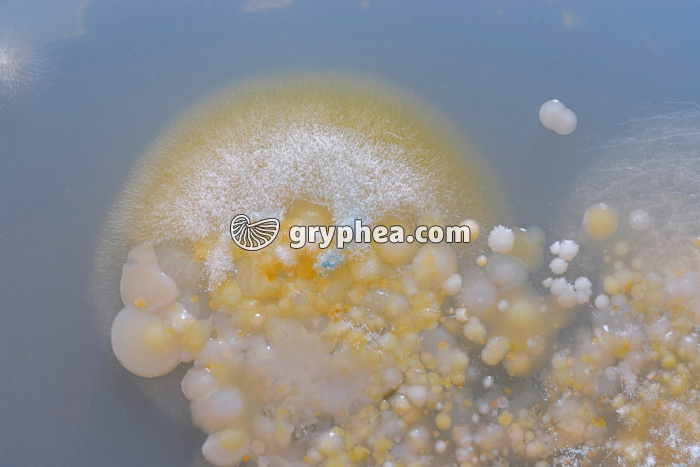
Moisissures et colonies bactériennes sur gélose - gryphea.com

1 crédit = 6.00€ TTC
(Hors pack)
si vous êtes enseignant, le site gryphea.org a été conçu spécialement pour vous !
Colonies bactériennes et moisissures
La contamination d'une boite de culture est un cas assez courant en microbiologie, qui aboutit généralement à l'élimination de la culture. En effet, l’air qui nous entoure, intérieur comme extérieur, véhicule naturellement des spores de moisissures qui se déposent un peu partout au gré des courants d’air. Lors de l’ensemencement d’une boite de Pétri, il peut arriver qu’une ou plusieurs spores, bactérienne ou fongique, pénètre à l’intérieur et contamine la culture. Celle-ci devient alors impropre à l'étude.
Ici, plusieurs champignons microscopiques, ou moisissures, ainsi que des bactéries se sont développés sur la gélose nutritive d'une boite de Pétri, dont on a laissé le couvercle ouvert à l'air libre pendant 2 minutes. Quelques microorganismes présents dans l'air ambiant, comme des bactéries, ainsi que des spores de moisissures, se sont alors déposés sur le milieu de culture. Après 72h de séjour en étuve, la boite de culture présente des colonies variées, reflet de la diversité des germes présents dans l'air du laboratoire (et plus généralement l'air que nous respirons). Cette expérience est une incitation à respecter des procédures strictes lors de l'ensemencement des boites de Pétri, afin de réussir les cultures de microorganismes (conditions stériles notamment).
Les colonies de moisissures se reconnaissent à leur aspect duveteux et la présence de nombreux filaments fins (hyphes).
Les colonies bactériennes sont plus ramassées, parfois globuleuses, et leurs contours sont généralement nets.
...La suite du commentaire est réservée aux inscrits, créez un compte gratuitement.